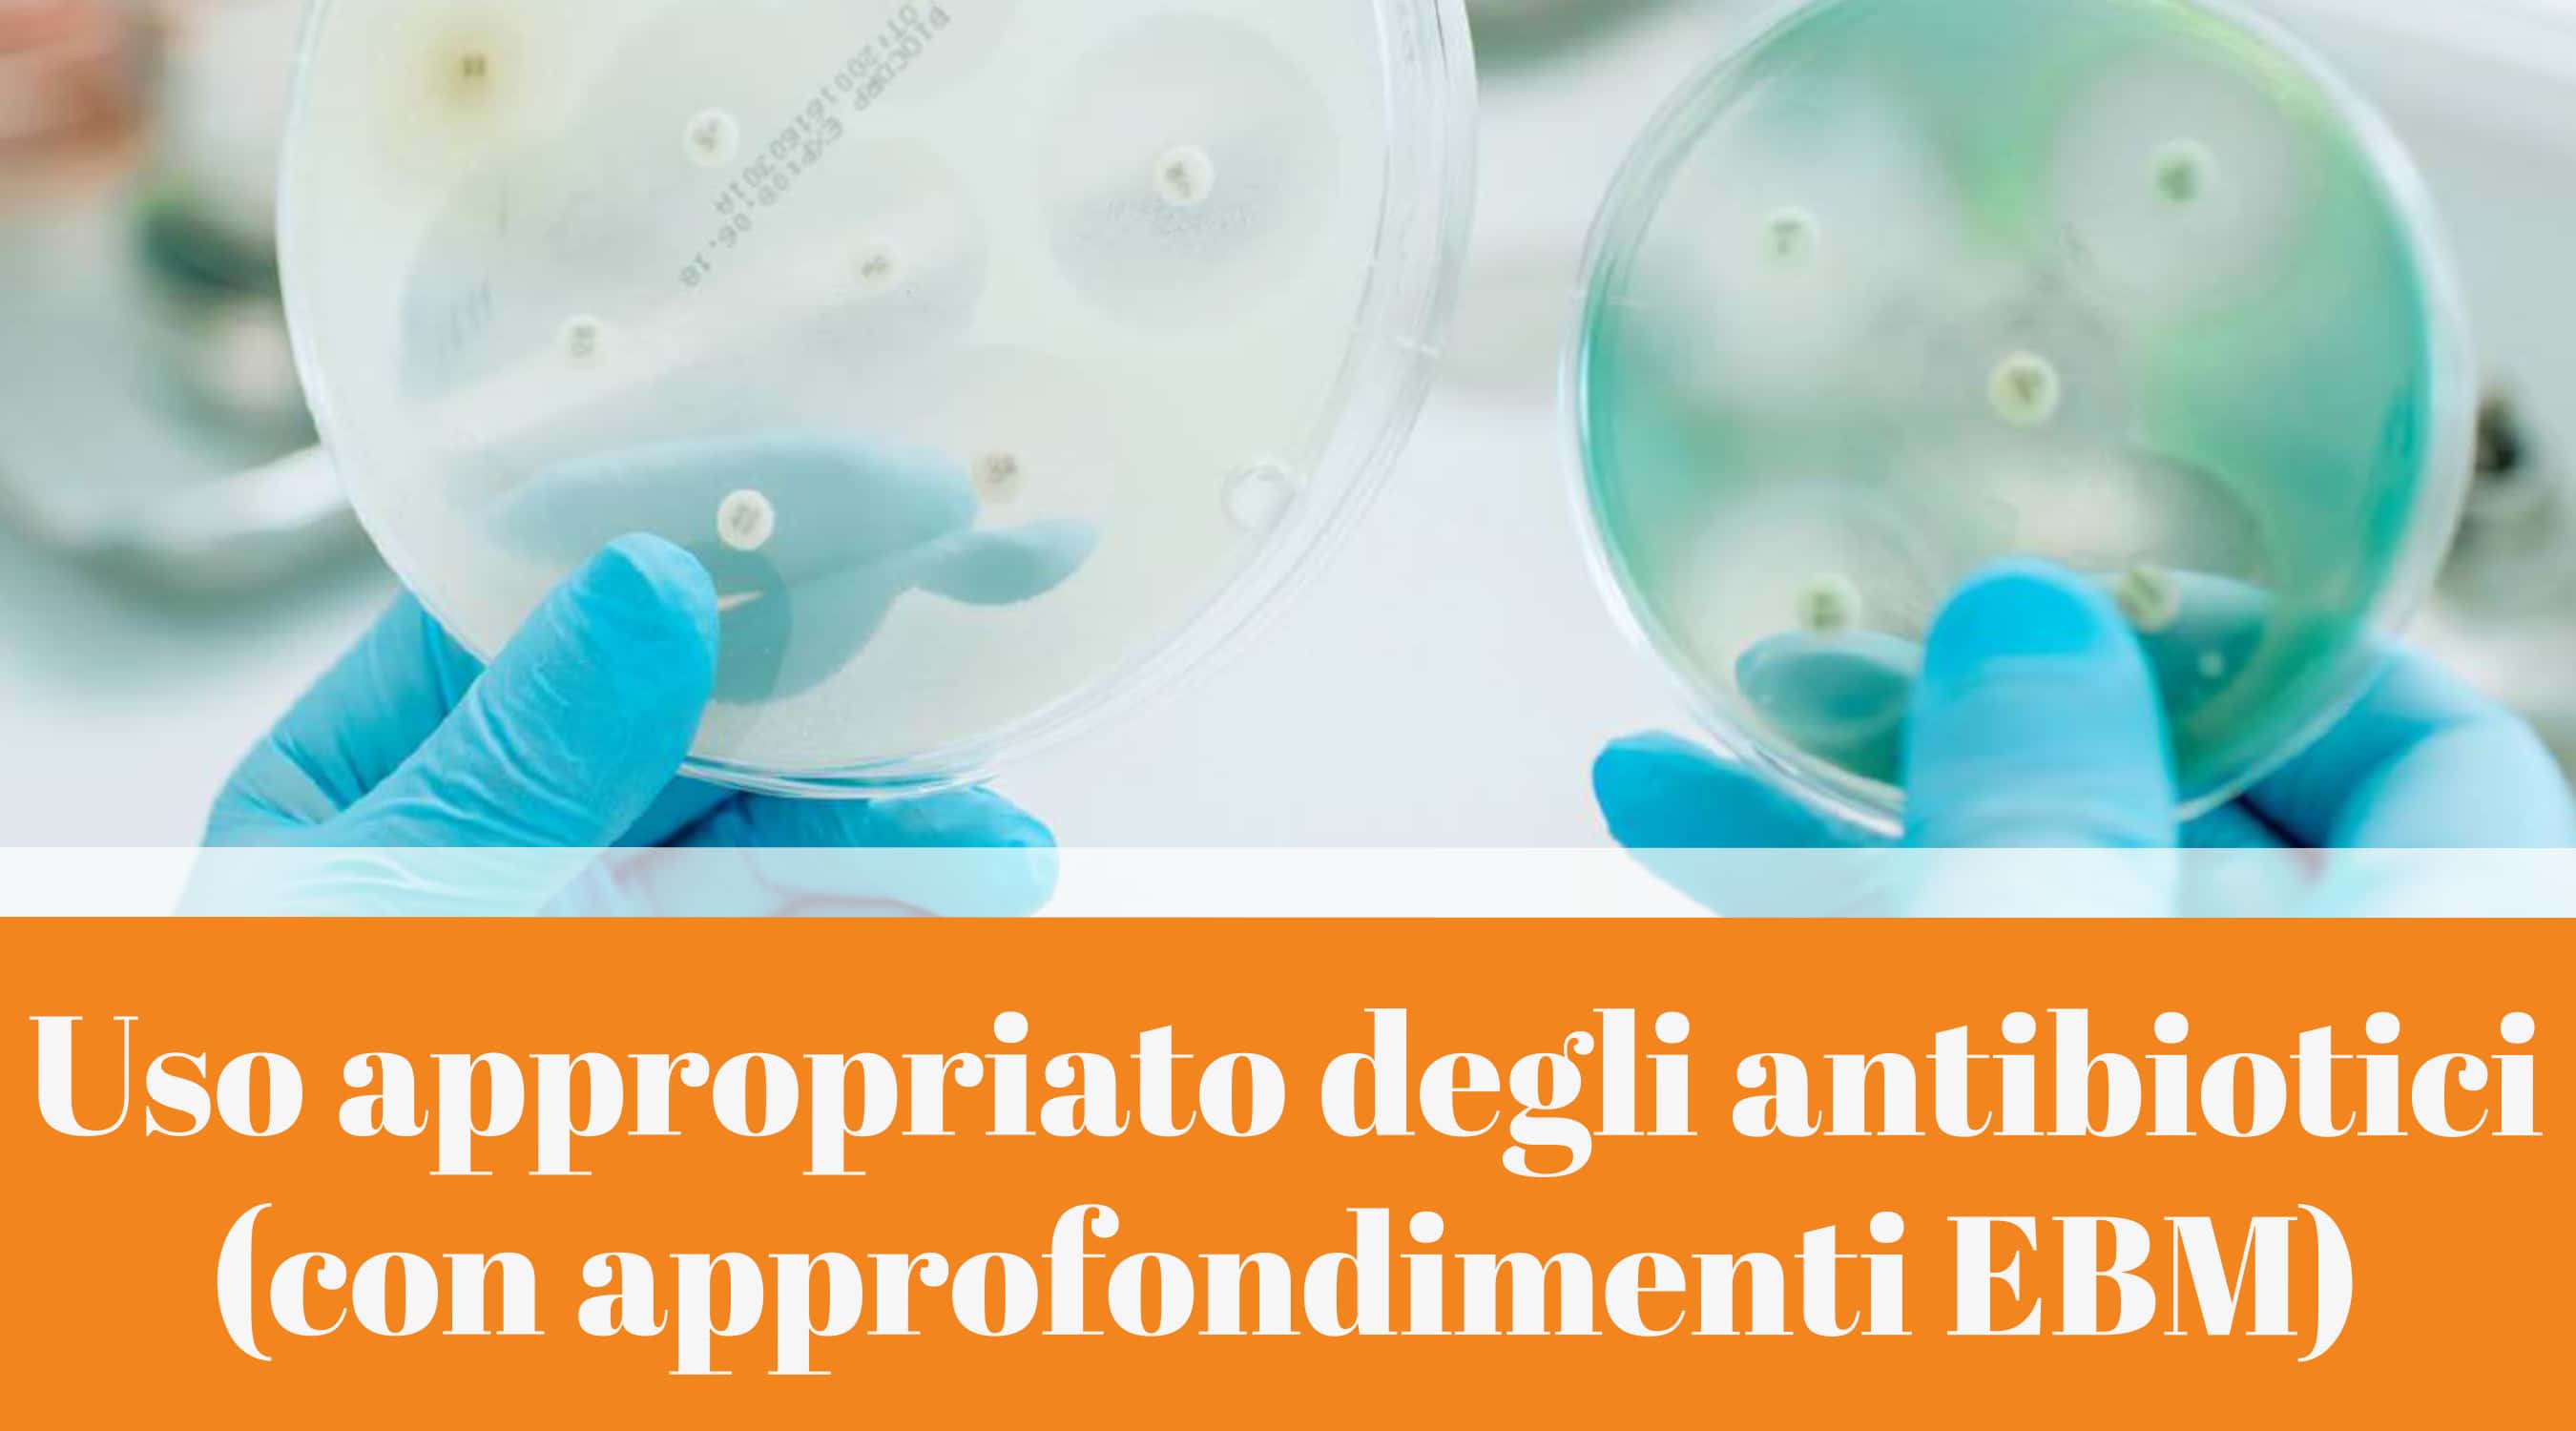
Clicca per accedere all'articolo Corso FAD "Uso appropriato degli antibiotici (con approfondimenti EBM)"

In relazione al progetto di informazione indipendente COSIsiFA, la Regione Emilia Romagna comunica che, a partire dal 5 novembre 2025, è disponibile - in modalità asincrona- sul sito Homepage - InFarmaco, sezione Formazione, per tutti gli operatori sanitari, il corso FAD “Uso appropriato degli antibiotici (con approfondimenti EBM)”.
Corsi e convegni nazionali
“Healthy Aging con HIV: costruire percorsi di cura Integrati per il futuro”
Webinar gratuito in programma il 20 dicembre 2025 organizzato dal Prof. Giovanni Guaraldi, dirigente medico della Stuttura Complessa di Malattie Infettive dell’Azienda Ospedaliero-Universitaria di Modena.
Il contrasto One Health all’antimicrobico resistenza in Emilia-Romagna
in occasione della settimana mondiale di sensibilizzazione sulla resistenza antimicrobica promossa dall’Organizzazione Mondiale della Sanità, la Regione Emilia-Romagna organizza un convegno sull’antimicrobico resistenza (AMR)in ottica One Health, mercoledì 10 dicembre dalle ore 9 alle ore 16 presso l’Aula Magna di Viale Aldo Moro 30, a Bologna.
Management multidisciplinare nella gestione delle pazienti con cancro della mammella: le pazienti ad alto rischio
Evento in programma il 5 dicembre 2025 a Piacenza presso il Best Western Park Hotel (Strada Val Nure 7).
Corso FAD ECM: “Radioprotezione in Sanità: Sicurezza, Norme e Buone Pratiche”
Corso in modalità FAD asincrona, strutturato in sei moduli didattici, accessibile sino al 31/12/2025. E' rivolto a infermieri, medici di base, tecnici di radiologia medica, medici specialisti, odontoiatri, medici veterinari, fisici.
Corso FAD “Dispositivo-Vigilanza: normativa e gestione delle segnalazioni sui dispositivi medici e diagnostici in vitro”
La Regione Emilia Romagna informa che è disponibile il corso regionale dal titolo “Dispositivo-Vigilanza: normativa e gestione delle segnalazioni sui dispositivi medici e diagnostici in vitro”.